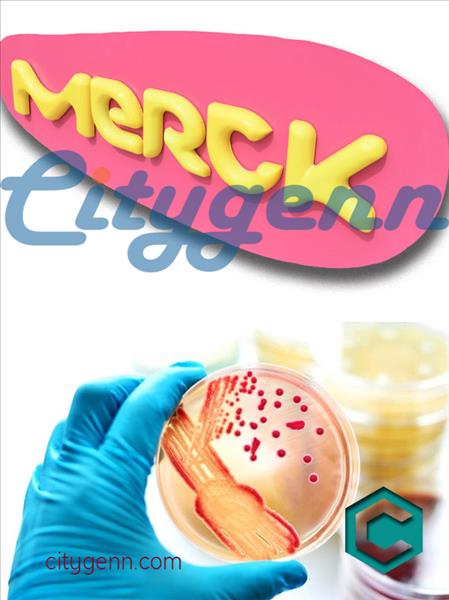

محیط کشت XLD آگار کد 105287 مرک آلمان
نام کالا انگلیسی :GranuCult Xylose Lysine Deoxycholate agar acc. ISO 6579, ISO 19250, and APHA, suitable for microbiology
کد کالا :1.05287
کمپانی :میلیپور
وزن/جرم ملکولی :-
قیمت و دسترسی
| شماره کاتالوگ | واحد کالا | قیمت | واحد | سفارش | |
| 1.05287.0500 | 500G | تومان | |||
| جهت آگاهی از قیمت کالا با کارشناسان ما تماس حاصل فرمایید | |||||
محیط کشت XLD آگار کد 105287 مرک آلمان
زایلوز لایزین دئوکسی کلرات آگار
GranuCult Xylose Lysine Deoxycholate agar
acc. ISO 6579, ISO 19250, and APHA, suitable for microbiology
Synonym(s): XLD agar
Analysis Note
Appearance (clearness): clear to slightly opalescent
Appearance (colour): red
pH-value (25 °C): 7.2 - 7.6
Growth promotion test in accordance with the current version of DIN EN ISO 11133.
Inoculum on reference medium (Salmonella typhimurium ATCC 14028 (WDCM 00031)):
Inoculum on reference medium (Salmonella enteritidis ATCC 13076 (WDCM 00030)):
Colony count (Salmonella typhimurium ATCC 14028 (WDCM 00031)):
Colony count (Salmonella enteritidis ATCC 13076 (WDCM 00030)): Recovery on test medium (Salmonella typhimurium ATCC 14028 (WDCM 00031)): ≥ 50 %
Recovery on test medium (Salmonella enteritidis ATCC 13076 (WDCM 00030)): ≥ 50 %
Growth (Escherichia coli ATCC 25922 (WDCM 00013)): Growth or partial inhibition
Growth (Escherichia coli ATCC 8739 (WDCM 00012)): Growth or partial inhibition
Growth (Enterococcus faecalis ATCC 29212 (WDCM 00087)): total inhibition
Growth (Enterococcus faecalis ATCC 19433 (WDCM 00009)): total inhibition
Colonies (Salmonella typhimurium ATCC 14028 (WDCM 00031)): Colonies with black centre
Colonies (Salmonella enteritidis ATCC 13076 (WDCM 00030)): Colonies with black centre
Colonies (Escherichia coli ATCC 25922 (WDCM 00013)): Yellow colonies
Colonies (Escherichia coli ATCC 8739 (WDCM 00012)): Yellow colonies
Incubation: 24 ± 3 hours at 37 ± 1 °C A recovery rate of 50 % is equivalent to a productivity value of 0.5.
The indicated colony counts result from the sum of a triple determination.
Reference media: Tryptic Soy Agar
Agency
APHA
ISO 19250
ISO 6579
Quality Level
form
medium granules (dehydrated (DCM))
manufacturer/tradename
GranuCult®
technique(s)
microbiological culture: suitable
pH
7.2-7.6 (25 °C, 55 g/L in H2O)
solubility
55 g/L
application(s)
food and beverages
microbiology
storage temp.
15-25°C
suitability
Salmonella spp.
